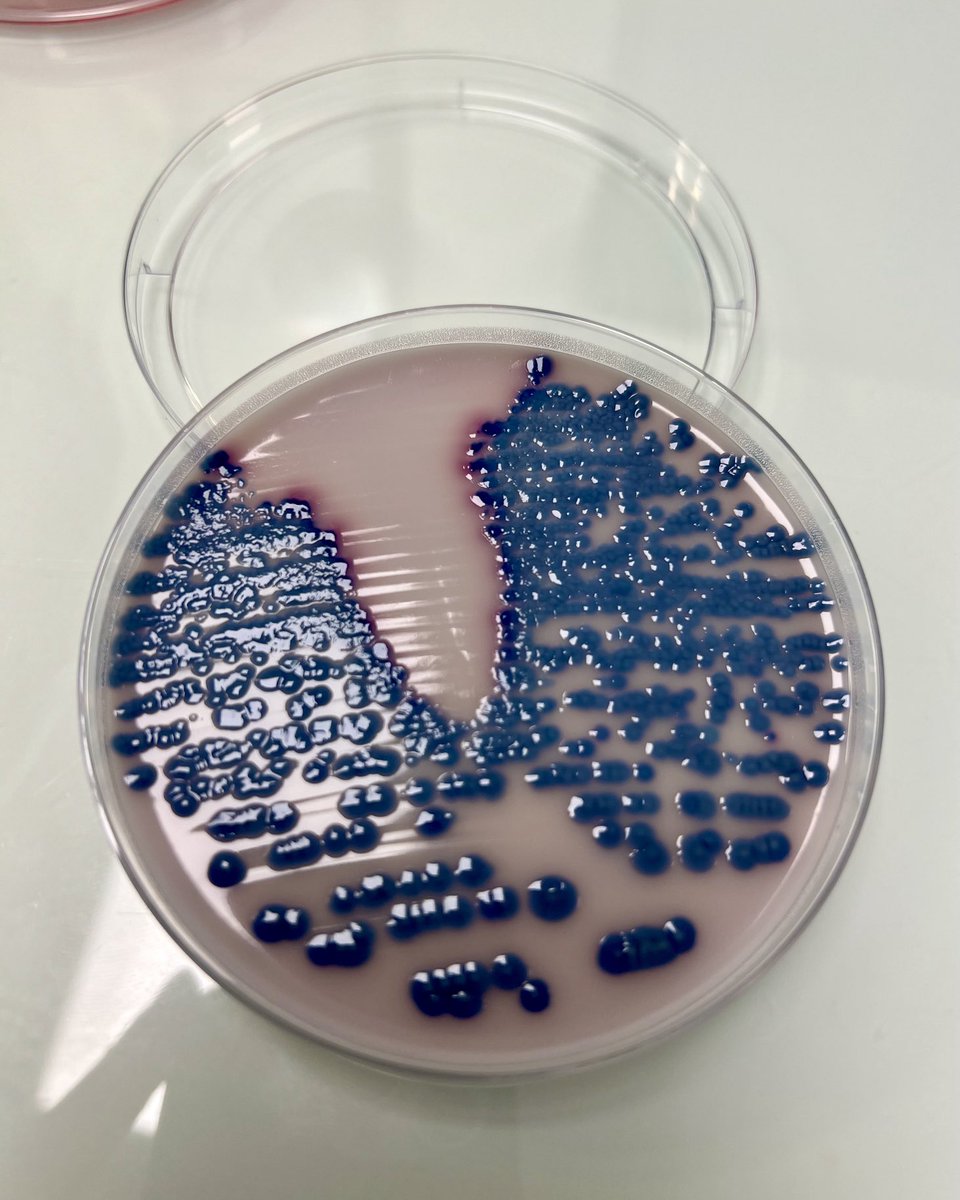
Geneviève HéryArnaud tweet media

William Peron
246 posts

William Peron
@WPeron1
Pharmacien hospitalier, passionné d'infectiologie et de bon usage des antibiotiques. Bretagne plus belle région de france
Katılım Ocak 2017
493 Takip Edilen48 Takipçiler

(FINAL)
Part 4 of my Twilight vs Thorn Princess fancomic!
1/8
#SPYxFamily #spyxfamilyfanart #loidyor #YorForger #loidforger #AnyaForger #SPY_FAMILY

English

@Whitekirbyx @Topiramatee Pour travailler dans une PUI, il faut obligatoirement le DES de pharmacie Hospitalière, que l'on obtient après 4 ans d'internat en pharmacie.
Français

Petit à petit, mes ami.es de la fac reprennent une pharmacie et deviennent titulaires.
Je ne vous cache pas que je ne peux m’empêcher d’avoir des moments où j’ai l’impression de ne pas avancer.
Le truc, c’est que je ne souhaite pas devenir titulaire.
Pharmacien titulaire, c’est être chef d’entreprise. Je pense que je ne suis pas faite pour ça. Et les tâches inhérentes à ce statut ne me plaisent pas.
Mais du coup, quand on est pharmacien adjoint, je m’aperçois peu à peu qu’on est bloqués dans notre boulot.
➡️ bosser à l’hôpital ? Ce n’est plus possible.
➡️ bosser dans l’industrie ? C’est déjà hyper compétitif pour ceux qui ont choisi cette orientation dès le départ avec master adéquat, alors pour un pharmacien d’officine …. 🤷🏻♀️
Il y a bien d’autres débouchés mais c’est assez « niche » (oxygène médical, grossistes, enseignement…)
Bref, là à l’instant t, ce que je fais me plaît, mais quand je me projette dans 10 ans, j’ai du mal à m’imaginer être encore au même poste.
Bien sûr on peut développer des choses au sein de la pharmacie, moi j’aime beaucoup la pharmacie clinique. Mais j’ai la sensation qu’on ne peut jamais se poser pour réfléchir, organiser et mettre en place cela. On est constamment hapés par le comptoir.
En plus, j’ai le sentiment que notre génération n’aura pas de retraite ou bien à 70 ans. Donc il va falloir bosser longtemps.
Une option serait de se réorienter à moyen terme, mais pour faire quoi ?
🤔🤔🤔
Français

@Luluterus_mom Est-ce qu'il y a autant de drama que dans grey's Anatomy ? 😀
Français

@lometrexate Quand j'étais interne au CHU d'Angers, on en faisait pour l'ophtalmo 😁
Français

@PtitBibi300 est-ce que tu as vu la série Devil May Cry Netflix ? Si non, fonce. La série est plutôt cool et l'épisode 6 est une grosse masterclass 👌
Français

@Polardov Quand on voit en plus la grosse épidémie de rougeole qui se propage dans 7 états, on constate que c'est que le début des soucis. Surtout si on ajoute en plus l'annexion du Canada et du Groenland.
Français

@charles_cazanav @ossauiraty @TF1 @ossau_info @HalleIraty @sebastien_gard @Genevieve_Hery @yannbubien Bonnes fêtes à vous également 🎉🎊
Français

L’#OssauIraty @ossauiraty décerné meilleur fromage de 🇫🇷 !
Quelle fierté pour le #PaysBasque & le #Béarn où est produit ce fromage à partir du lait de brebis. Mon fromage préféré ;-)
J’espère qu’il agrémentera vos plateaux de fête 🍾 !
Joyeuses fêtes à toutes & tous !

Français

@Genevieve_Hery @milliezach @CHU_Brest Ça me rappelle les vieux panneaux de la Corpo pharma Toulouse 😂 #Faluche
Français

Le 🎅 est passé en avance au Département des Agents Infectieux du @CHU_Brest 🎁 (et oui, le plus gros paquet était pour moi 😉)
Joyeuses fêtes ! 🎊🎄✨

Français

@Genevieve_Hery Ça pourrait être également paris après 3 bouteilles de cidre brut 😂
Français


@Sebbyy78 Si tu dis a des Bretons que Nantes, c'est la Bretagne, tu t'avances sur un terrain glissant 😂
Français


@charles_cazanav @CHUBordeaux Vous avez de la neige a Bordeaux ? 😁
Français

#sunrise
Jolies couleurs hivernales sur le @CHUBordeaux !
Bonne journée et attention ⚠️ froid, neige…

Français

@Genevieve_Hery @VendeeGlobe @JeanLecam @Toutcommence29 @armor_lux C'est normal. Quand tu as le Finistère en sponsor, tu ne peux que gagner 👌
Français

.@VendeeGlobe Le roi @JeanLecam 👑 n'en finit pas de nous épater ! Bon, on sent que la flotte de l'Ouest va revenir pleine balle ces prochaines heures, mais quel plaisir de voir le beau @Toutcommence29 @armor_lux en 1ère position depuis vendredi. Long is the race! #VG2024

Français


@Polardov Il faut garder espoir jusqu'au bout.
Si les actions de Trump ont un impact négatif sur le porte monnaie des américains, il perdra leur soutien.
Français

@Polardov Personnellement, j'ai très peur de l'influence que peut avoir RJK jr sur la santé publique.
La désinformation médicale via les réseaux sociaux est un fléau.
Français

@Polardov Je pense également que Trump va échapper à la justice et sans vouloir être pessimiste, le procès de Géorgie va être mort et enterré.
Il manque plus que RFK jr soit au gouvernement et annonce la fin de la vaccination aux USA pour toucher encore plus le fond.
Français